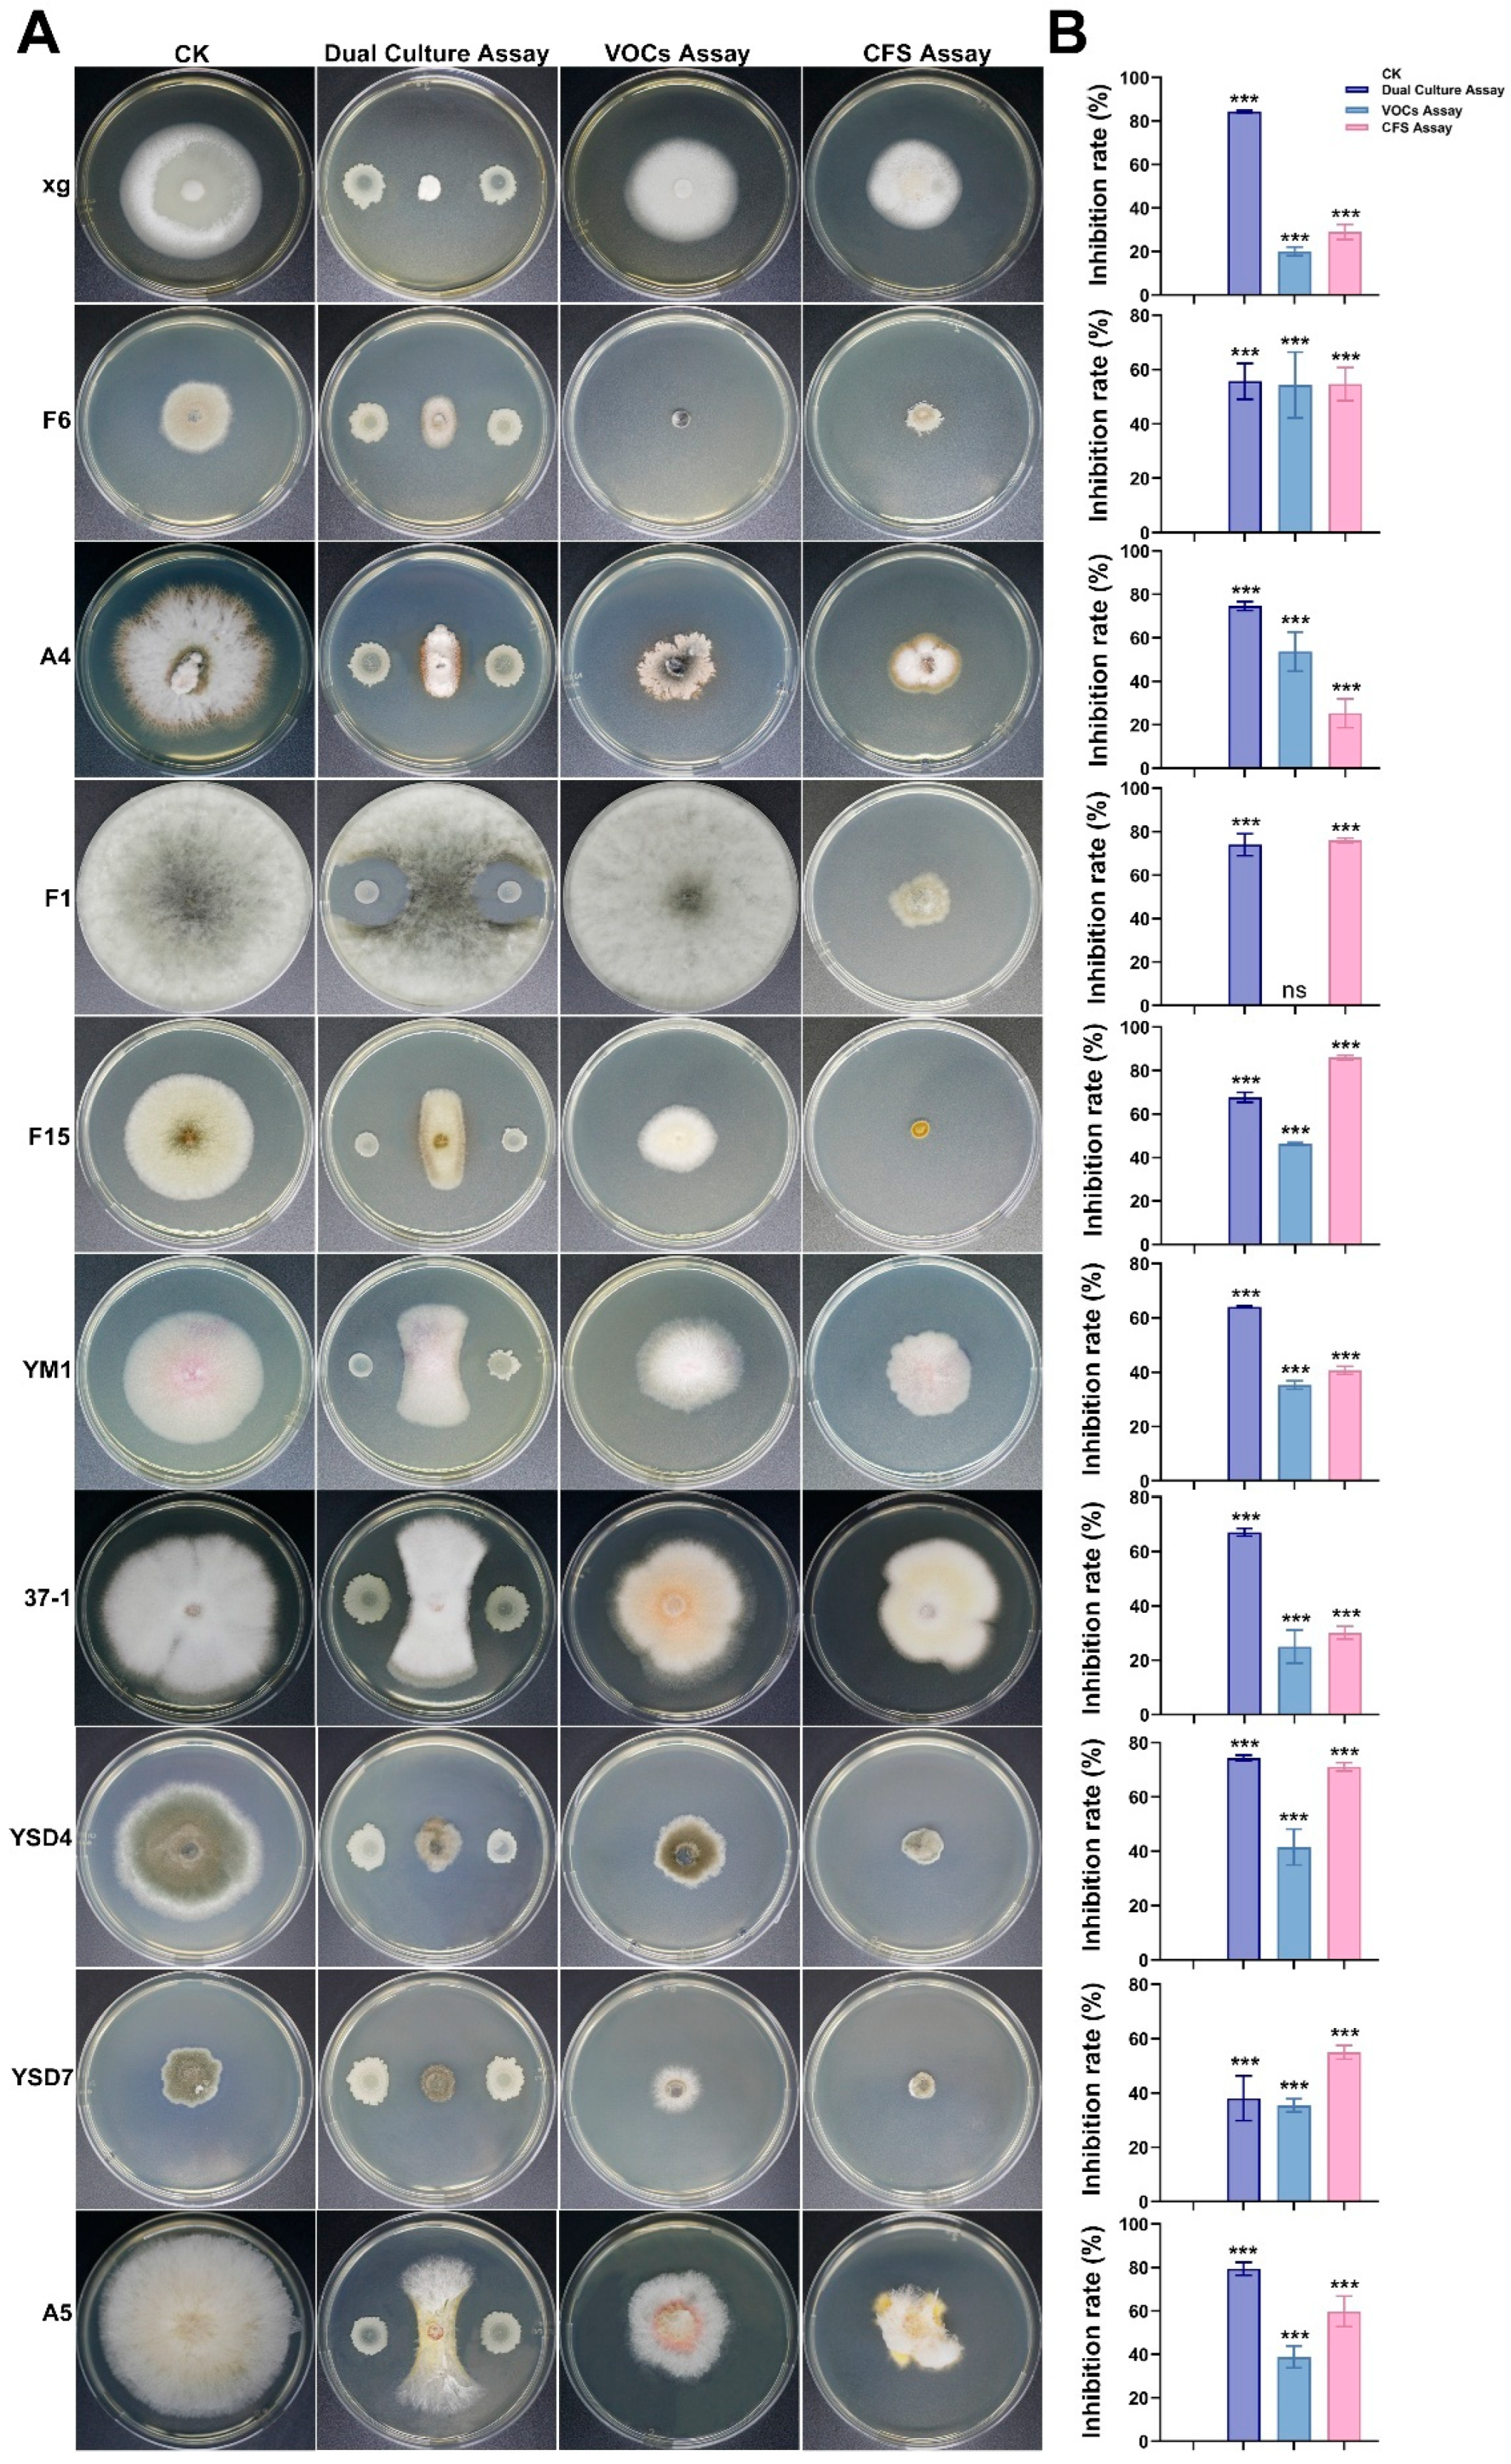
Microorganisms 13 02701 g005a

Isolation and Genome-Based Characterization of Bacillus velezensis AN6 for Its Biocontrol Potential Against Multiple Plant Pathogens
Abstract
1. Introduction
2. Materials and Methods
2.1. Bacterium and Pathogens Used in This Study
2.2. Isolation and Morphological Observation of Endophytic Bacteria
2.3. Screening of Biocontrol Strains with Resistance to Xanthomonas oryzae pv. oryzae
2.4. Morphological and Biological Characteristics of the Strain AN6
2.5. The Effect of Sterile AN6 Cell-Free Supernatant on the Cell Growth of Xoo
2.6. Detection of Protease Production and Iron Chelation Ability of AN6
2.7. Evaluation of Biocontrol Efficacy in a Light Incubator
2.8. Evaluation of the Antifungal Spectrum of Antagonistic Strain AN6
2.9. Genome Sequencing and Analysis
2.10. Comparative Genomic Analysis
2.11. Statistical Analysis
3. Results
3.1. Isolation and Screening of Bacillus
3.2. Morphological and Biological Characteristics of the Isolated Strain AN6
3.3. Antagonistic Activity of AN6 Strain Cell-Free Supernatant
3.4. Biocontrol Effect of AN6 Against Xoo
3.5. Antifungal Activity of Strain AN6 In Vitro
3.6. Complete Genome Sequence and Biosynthesis Gene Clusters of Strain AN6
3.7. Comparative Genomics Analysis
4. Discussion
5. Conclusions
Supplementary Materials
Author Contributions
Funding
Institutional Review Board Statement
Informed Consent Statement
Data Availability Statement
Conflicts of Interest
References
- Zeng, D.; Tian, Z.; Rao, Y.; Dong, G.; Yang, Y.; Huang, L.; Leng, Y.; Xu, J.; Sun, C.; Zhang, G.; et al. Rational design of high-yield and superior-quality rice. Nat. Plants 2017, 3, 17031. [Google Scholar] [CrossRef] [PubMed]
- Zeigler, R.S.; Barclay, A. The Relevance of Rice. Rice 2008, 1, 3–10. [Google Scholar] [CrossRef]
- Niño-Liu, D.O.; Ronald, P.C.; Bogdanove, A.J. Xanthomonas oryzae pathovars: Model pathogens of a model crop. Mol. Plant Pathol. 2006, 7, 303–324. [Google Scholar] [CrossRef] [PubMed]
- Mansfield, J.; Genin, S.; Magori, S.; Citovsky, V.; Sriariyanum, M.; Ronald, P.; Dow, M.; Verdier, V.; Beer, S.V.; Machado, M.A.; et al. Top 10 plant pathogenic bacteria in molecular plant pathology. Mol. Plant Pathol. 2012, 13, 614–629. [Google Scholar] [CrossRef]
- Kou, Y.; Wang, S. Broad-spectrum and durability: Understanding of quantitative disease resistance. Curr. Opin. Plant Biol. 2010, 13, 181–185. [Google Scholar] [CrossRef]
- Ramalingam, J.; Savitha, P.; Alagarasan, G.; Saraswathi, R.; Chandrababu, R. Functional Marker Assisted Improvement of Stable Cytoplasmic Male Sterile Lines of Rice for Bacterial Blight Resistance. Front. Plant Sci. 2017, 8, 1131. [Google Scholar] [CrossRef]
- Tian, Y.; Zhao, Y.; Xu, R.; Liu, F.; Hu, B.; Walcott, R.R. Simultaneous Detection of Xanthomonas oryzae pv. oryzae and X. oryzae pv. oryzicola in Rice Seed Using a Padlock Probe-Based Assay. Phytopathology 2014, 104, 1130–1137. [Google Scholar] [CrossRef]
- Namburi, K.R.; Kora, A.J.; Chetukuri, A.; Kota, V. Biogenic silver nanoparticles as an antibacterial agent against bacterial leaf blight causing rice phytopathogen Xanthomonas oryzae pv. oryzae. Bioprocess. Biosyst. Eng. 2021, 44, 1975–1988. [Google Scholar] [CrossRef]
- Gerhardson, B. Biological substitutes for pesticides. Trends Biotechnol. 2002, 20, 338–343. [Google Scholar] [CrossRef]
- Wu, L.; Wu, H.J.; Qiao, J.; Gao, X.; Borriss, R. Novel Routes for Improving Biocontrol Activity of Bacillus Based Bioinoculants. Front. Microbiol. 2015, 6, 1395. [Google Scholar] [CrossRef]
- Choudhary, D.K.; Johri, B.N. Interactions of Bacillus spp. and plants—With special reference to induced systemic resistance (ISR). Microbiol. Res. 2009, 164, 493–513. [Google Scholar] [CrossRef]
- de Boer, M.; Bom, P.; Kindt, F.; Keurentjes, J.J.; van der Sluis, I.; van Loon, L.C.; Bakker, P.A. Control of Fusarium Wilt of Radish by Combining Pseudomonas putida Strains that have Different Disease-Suppressive Mechanisms. Phytopathology 2003, 93, 626–632. [Google Scholar] [CrossRef]
- McSpadden Gardener, B.B. Ecology of Bacillus and Paenibacillus spp. in Agricultural Systems. Phytopathology 2004, 94, 1252–1258. [Google Scholar] [CrossRef]
- Kloepper, J.W.; Ryu, C.M.; Zhang, S. Induced Systemic Resistance and Promotion of Plant Growth by Bacillus spp. Phytopathology 2004, 94, 1259–1266. [Google Scholar] [CrossRef] [PubMed]
- Koumoutsi, A.; Chen, X.H.; Henne, A.; Liesegang, H.; Hitzeroth, G.; Franke, P.; Vater, J.; Borriss, R. Structural and functional characterization of gene clusters directing nonribosomal synthesis of bioactive cyclic lipopeptides in Bacillus amyloliquefaciens strain FZB42. J. Bacteriol. 2004, 186, 1084–1096. [Google Scholar] [CrossRef] [PubMed]
- Wang, G.F.; Meng, J.F.; Tian, T.; Xiao, X.Q.; Zhang, B.; Xiao, Y.N. Endophytic Bacillus velezensis strain B-36 is a potential biocontrol agent against lotus rot caused by Fusarium oxysporum. J. Appl. Microbiol. 2020, 128, 1153–1162. [Google Scholar] [CrossRef] [PubMed]
- Ji, S.H.; Paul, N.C.; Deng, J.X.; Kim, Y.S.; Yun, B.S.; Yu, S.H. Biocontrol Activity of Bacillus amyloliquefaciens CNU114001 against Fungal Plant Diseases. Mycobiology 2013, 41, 234–242. [Google Scholar] [CrossRef] [PubMed]
- Masum, M.M.I.; Liu, L.; Yang, M.; Hossain, M.M.; Siddiqa, M.M.; Supty, M.E.; Ogunyemi, S.O.; Hossain, A.; An, Q.; Li, B. Halotolerant bacteria belonging to operational group Bacillus amyloliquefaciens in biocontrol of the rice brown stripe pathogen Acidovorax oryzae. J. Appl. Microbiol. 2018, 125, 1852–1867. [Google Scholar] [CrossRef]
- Xu, Z.; Zhang, R.; Wang, D.; Qiu, M.; Feng, H.; Zhang, N.; Shen, Q. Enhanced control of cucumber wilt disease by Bacillus amyloliquefaciens SQR9 by altering the regulation of Its DegU phosphorylation. Appl. Environ. Microbiol. 2014, 80, 2941–2950. [Google Scholar] [CrossRef]
- Chung, S.; Kong, H.; Buyer, J.S.; Lakshman, D.K.; Lydon, J.; Kim, S.D.; Roberts, D.P. Isolation and partial characterization of Bacillus subtilis ME488 for suppression of soilborne pathogens of cucumber and pepper. Appl. Microbiol. Biotechnol. 2008, 80, 115–123. [Google Scholar] [CrossRef]
- Jia, K.; Gao, Y.-H.; Huang, X.-Q.; Guo, R.-J.; Li, S.-D. Rhizosphere Inhibition of Cucumber Fusarium Wilt by Different Surfactin- excreting Strains of Bacillus subtilis. Plant Pathol. J. 2015, 31, 140–151. [Google Scholar] [CrossRef] [PubMed]
- Nikolić, I.; Berić, T.; Dimkić, I.; Popović, T.; Lozo, J.; Fira, D.; Stanković, S. Biological control of Pseudomonas syringae pv. aptata on sugar beet with Bacillus pumilus SS-10.7 and Bacillus amyloliquefaciens (SS-12.6 and SS-38.4) strains. J. Appl. Microbiol. 2019, 126, 165–176. [Google Scholar] [CrossRef] [PubMed]
- Ryu, C.M.; Hu, C.H.; Reddy, M.S.; Kloepper, J.W. Different signaling pathways of induced resistance by rhizobacteria in Arabidopsis thaliana against two pathovars of Pseudomonas syringae. New Phytol. 2003, 160, 413–420. [Google Scholar] [CrossRef] [PubMed]
- Ruiz-García, C.; Béjar, V.; Martínez-Checa, F.; Llamas, I.; Quesada, E. Bacillus velezensis sp. nov., a surfactant-producing bacterium isolated from the river Vélez in Málaga, southern Spain. Int. J. Syst. Evol. Microbiol. 2005, 55, 191–195. [Google Scholar] [CrossRef]
- Chen, X.H.; Koumoutsi, A.; Scholz, R.; Borriss, R. More than anticipated—Production of antibiotics and other secondary metabolites by Bacillus amyloliquefaciens FZB42. J. Mol. Microbiol. Biotechnol. 2009, 16, 14–24. [Google Scholar] [CrossRef]
- Toral, L.; Rodríguez, M.; Béjar, V.; Sampedro, I. Crop Protection against Botrytis cinerea by Rhizhosphere Biological Control Agent Bacillus velezensis XT1. Microorganisms 2020, 8, 992. [Google Scholar] [CrossRef]
- Balderas-Ruíz, K.A.; Bustos, P.; Santamaria, R.I.; González, V.; Cristiano-Fajardo, S.A.; Barrera-Ortíz, S.; Mezo-Villalobos, M.; Aranda-Ocampo, S.; Guevara-García, Á.A.; Galindo, E.; et al. Bacillus velezensis 83 a bacterial strain from mango phyllosphere, useful for biological control and plant growth promotion. AMB Express 2020, 10, 163. [Google Scholar] [CrossRef]
- Choub, V.; Ajuna, H.B.; Won, S.J.; Moon, J.H.; Choi, S.I.; Maung, C.E.H.; Kim, C.W.; Ahn, Y.S. Antifungal Activity of Bacillus velezensis CE 100 against Anthracnose Disease (Colletotrichum gloeosporioides) and Growth Promotion of Walnut (Juglans regia L.) Trees. Int. J. Mol. Sci. 2021, 22, 10438. [Google Scholar] [CrossRef]
- Choub, V.; Maung, C.E.H.; Won, S.J.; Moon, J.H.; Kim, K.Y.; Han, Y.S.; Cho, J.Y.; Ahn, Y.S. Antifungal Activity of Cyclic Tetrapeptide from Bacillus velezensis CE 100 against Plant Pathogen Colletotrichum gloeosporioides. Pathogens 2021, 10, 209. [Google Scholar] [CrossRef]
- Kim, Y.S.; Lee, Y.; Cheon, W.; Park, J.; Kwon, H.T.; Balaraju, K.; Kim, J.; Yoon, Y.J.; Jeon, Y. Characterization of Bacillus velezensis AK-0 as a biocontrol agent against apple bitter rot caused by Colletotrichum gloeosporioides. Sci. Rep. 2021, 11, 626. [Google Scholar] [CrossRef]
- Yan, H.; Qiu, Y.; Yang, S.; Wang, Y.; Wang, K.; Jiang, L.; Wang, H. Antagonistic Activity of Bacillus velezensis SDTB038 against Phytophthora infestans in Potato. Plant Dis. 2021, 105, 1738–1747. [Google Scholar] [CrossRef]
- Chen, L.; Wang, X.; Ma, Q.; Bian, L.; Liu, X.; Xu, Y.; Zhang, H.; Shao, J.; Liu, Y. Bacillus velezensis CLA178-Induced Systemic Resistance of Rosa multiflora Against Crown Gall Disease. Front. Microbiol. 2020, 11, 587667. [Google Scholar] [CrossRef] [PubMed]
- Ben Gharsa, H.; Bouri, M.; Mougou Hamdane, A.; Schuster, C.; Leclerque, A.; Rhouma, A. Bacillus velezensis strain MBY2, a potential agent for the management of crown gall disease. PLoS ONE 2021, 16, e0252823. [Google Scholar] [CrossRef] [PubMed]
- Cao, Y.; Pi, H.; Chandrangsu, P.; Li, Y.; Wang, Y.; Zhou, H.; Xiong, H.; Helmann, J.D.; Cai, Y. Antagonism of Two Plant-Growth Promoting Bacillus velezensis Isolates Against Ralstonia solanacearum and Fusarium oxysporum. Sci. Rep. 2018, 8, 4360. [Google Scholar] [CrossRef]
- Luo, W.; Liu, L.; Qi, G.; Yang, F.; Shi, X.; Zhao, X. Embedding Bacillus velezensis NH-1 in Microcapsules for Biocontrol of Cucumber Fusarium Wilt. Appl. Environ. Microbiol. 2019, 85, e03128-18. [Google Scholar] [CrossRef]
- Pajčin, I.; Vlajkov, V.; Frohme, M.; Grebinyk, S.; Grahovac, M.; Mojićević, M.; Grahovac, J. Pepper Bacterial Spot Control by Bacillus velezensis: Bioprocess Solution. Microorganisms 2020, 8, 1463. [Google Scholar] [CrossRef]
- Jin, P.; Wang, Y.; Tan, Z.; Liu, W.; Miao, W. Antibacterial activity and rice-induced resistance, mediated by C(15)surfactin A, in controlling rice disease caused by Xanthomonas oryzae pv. oryzae. Pestic. Biochem. Physiol. 2020, 169, 104669. [Google Scholar] [CrossRef]
- Ding, H.; Mo, W.; Yu, S.; Cheng, H.; Peng, L.; Liu, Z. Whole Genome Sequence of Bacillus velezensis Strain GUMT319: A Potential Biocontrol Agent Against Tobacco Black Shank Disease. Front. Microbiol. 2021, 12, 658113. [Google Scholar] [CrossRef]
- Abd El-Daim, I.A.; Bejai, S.; Meijer, J. Bacillus velezensis 5113 Induced Metabolic and Molecular Reprogramming during Abiotic Stress Tolerance in Wheat. Sci. Rep. 2019, 9, 16282. [Google Scholar] [CrossRef]
- Njoloma, J.P.B. Isolation of Endophytic Bacteria from Leaves, Stems, or Roots. In Endophytic Microbes: Isolation, Identification, and Bioactive Potentials; Sankaranarayanan, A., Amaresan, N., Dwivedi, M.K., Eds.; Springer: New York, NY, USA, 2023; pp. 3–6. [Google Scholar] [CrossRef]
- Liu, X.; Lu, Z.; Ma, Z.; Yu, T.; Chen, H.; Wang, L.; Chen, X. Antagonistic activity and application of Bacillus velezensis strain Bv-303 against rice bacterial-blight disease caused by Xanthomonas oryzae pv. oryzae. Sheng Wu Gong Cheng Xue Bao 2023, 39, 741–754. [Google Scholar] [CrossRef]
- Fan, J.; Qian, G.; Chen, T.; Zhao, Y.; Liu, F.; Hu, W.B. The acyl-homoserine lactone (AHL)-type quorum sensing system affects growth rate, swimming motility and virulence in Acidovorax avenae subsp. citrulli. World J. Microbiol. Biotechnol. 2011, 27, 1155–1166. [Google Scholar] [CrossRef]
- Ke, Y.; Hui, S.; Yuan, M. Xanthomonas oryzae pv. oryzae Inoculation and Growth Rate on Rice by Leaf Clipping Method. Bio-Protoc. 2017, 7, e2568. [Google Scholar] [CrossRef] [PubMed]
- Lim, H.J.; Lee, E.H.; Yoon, Y.; Chua, B.; Son, A. Portable lysis apparatus for rapid single-step DNA extraction of Bacillus subtilis. J. Appl. Microbiol. 2016, 120, 379–387. [Google Scholar] [CrossRef] [PubMed]
- Hyatt, D.; Chen, G.L.; Locascio, P.F.; Land, M.L.; Larimer, F.W.; Hauser, L.J. Prodigal: Prokaryotic gene recognition and translation initiation site identification. BMC Bioinform. 2010, 11, 119. [Google Scholar] [CrossRef] [PubMed]
- Chan, P.P.; Lin, B.Y.; Mak, A.J.; Lowe, T.M. tRNAscan-SE 2.0: Improved detection and functional classification of transfer RNA genes. Nucleic Acids Res. 2021, 49, 9077–9096. [Google Scholar] [CrossRef]
- Lagesen, K.; Hallin, P.; Rødland, E.A.; Staerfeldt, H.H.; Rognes, T.; Ussery, D.W. RNAmmer: Consistent and rapid annotation of ribosomal RNA genes. Nucleic Acids Res. 2007, 35, 3100–3108. [Google Scholar] [CrossRef]
- Reiner, J.; Pisani, L.; Qiao, W.; Singh, R.; Yang, Y.; Shi, L.; Khan, W.A.; Sebra, R.; Cohen, N.; Babu, A.; et al. Cytogenomic identification and long-read single molecule real-time (SMRT) sequencing of a Bardet-Biedl Syndrome 9 (BBS9) deletion. NPJ Genom. Med. 2018, 3, 3. [Google Scholar] [CrossRef]
- Blin, K.; Shaw, S.; Vader, L.; Szenei, J.; Reitz Zachary, L.; Augustijn Hannah, E.; Cediel-Becerra José, D.D.; de Crécy-Lagard, V.; Koetsier Robert, A.; Williams Sam, E.; et al. antiSMASH 8.0: Extended gene cluster detection capabilities and analyses of chemistry, enzymology, and regulation. Nucleic Acids Res. 2025, 53, W32–W38. [Google Scholar] [CrossRef]
- Richter, M.; Rosselló-Móra, R.; Oliver Glöckner, F.; Peplies, J. JSpeciesWS: A web server for prokaryotic species circumscription based on pairwise genome comparison. Bioinformatics 2016, 32, 929–931. [Google Scholar] [CrossRef]
- Meier-Kolthoff, J.P.; Carbasse, J.S.; Peinado-Olarte, R.L.; Göker, M. TYGS and LPSN: A database tandem for fast and reliable genome-based classification and nomenclature of prokaryotes. Nucleic Acids Res. 2022, 50, D801–D807. [Google Scholar] [CrossRef]
- Konstantinidis, K.T.; Tiedje, J.M. Genomic insights that advance the species definition for prokaryotes. Proc. Natl. Acad. Sci. USA 2005, 102, 2567–2572. [Google Scholar] [CrossRef]
- Zhang, D.; Gao, F.; Jakovlić, I.; Zou, H.; Zhang, J.; Li, W.X.; Wang, G.T. PhyloSuite: An integrated and scalable desktop platform for streamlined molecular sequence data management and evolutionary phylogenetics studies. Mol. Ecol. Resour. 2020, 20, 348–355. [Google Scholar] [CrossRef]
- Kearse, M.; Moir, R.; Wilson, A.; Stones-Havas, S.; Cheung, M.; Sturrock, S.; Buxton, S.; Cooper, A.; Markowitz, S.; Duran, C.; et al. Geneious Basic: An integrated and extendable desktop software platform for the organization and analysis of sequence data. Bioinformatics 2012, 28, 1647–1649. [Google Scholar] [CrossRef]
- Darling, A.C.; Mau, B.; Blattner, F.R.; Perna, N.T. Mauve: Multiple alignment of conserved genomic sequence with rearrangements. Genome Res. 2004, 14, 1394–1403. [Google Scholar] [CrossRef] [PubMed]
- Qi, Y.; Rao, Q.; Lu, C.; Gong, J.; Hou, Y. Recent Progress in Rice–Xanthomonas oryzae Interactions. Biology 2025, 14, 471, Correction in Biology 2025, 14, 837. [Google Scholar] [CrossRef] [PubMed]
- Tan, J.; Zhao, H.; Li, J.; Gong, Y.; Li, X. The Devastating Rice Blast Airborne Pathogen Magnaporthe oryzae—A Review on Genes Studied with Mutant Analysis. Pathogens 2023, 12, 379. [Google Scholar] [CrossRef] [PubMed]
- Luo, J.; Zhang, N. Magnaporthiopsis, a new genus in Magnaporthaceae (Ascomycota). Mycologia 2013, 105, 1019–1029. [Google Scholar] [CrossRef]
- Liu, Y.; An, J.; Safdar, A.; Shen, Y.; Sun, Y.; Shu, W.; Tan, X.; Zhu, B.; Xiao, J.; Schirawski, J.; et al. Identification and Characterization of Nigrospora Species and a Novel Species, Nigrospora anhuiensis, Causing Black Leaf Spot on Rice and Wild Rice in the Anhui Province of China. J. Fungi 2024, 10, 156. [Google Scholar] [CrossRef]
- Liu, L.M.; Zhao, Y.; Zhang, Y.L.; Wang, L.; Hou, Y.X.; Huang, S.W. First Report of Leaf Spot Disease on Rice Caused by Epicoccum sorghinum in China. Plant Dis. 2020, 104, 2735. [Google Scholar] [CrossRef]
- Kaboré, K.H.; Kassankogno, A.I.; Tharreau, D. Brown Spot of Rice: Worldwide Disease Impact, Phenotypic and Genetic Diversity of the Causal Pathogen Bipolaris oryzae, and Management of the Disease. Plant Pathol. 2025, 74, 908–922. [Google Scholar] [CrossRef]
- Chen, J.; Cao, X.; Fu, X.; Zhou, M.; Chen, C.; Song, X. Pathogen Composition and Fungicide Sensitivity in Rice Spikelet Rot Disease. Plant Dis. 2025, 109, 1075–1082. [Google Scholar] [CrossRef]
- Qiu, J.; Gu, H.; Wang, S.; Ji, F.; He, C.; Jiang, C.; Shi, J.; Liu, X.; Shen, G.; Lee, Y.-W.; et al. A diverse Fusarium community is responsible for contamination of rice with a variety of Fusarium toxins. Food Res. Int. 2024, 195, 114987. [Google Scholar] [CrossRef]
- Ayaz, M.; Li, C.-H.; Ali, Q.; Zhao, W.; Chi, Y.-K.; Shafiq, M.; Ali, F.; Yu, X.-Y.; Yu, Q.; Zhao, J.-T.; et al. Bacterial and Fungal Biocontrol Agents for Plant Disease Protection: Journey from Lab to Field, Current Status, Challenges, and Global Perspectives. Molecules 2023, 28, 6735. [Google Scholar] [CrossRef]
- Haq, I.U.; Rahim, K.; Yahya, G.; Ijaz, B.; Maryam, S.; Paker, N.P. Eco-smart biocontrol strategies utilizing potent microbes for sustainable management of phytopathogenic diseases. Biotechnol. Rep. 2024, 44, e00859. [Google Scholar] [CrossRef]
- Dehbi, I.; Achemrk, O.; Ezzouggari, R.; El Jarroudi, M.; Mokrini, F.; Legrifi, I.; Belabess, Z.; Laasli, S.-E.; Mazouz, H.; Lahlali, R. Beneficial Microorganisms as Bioprotectants against Foliar Diseases of Cereals: A Review. Plants 2023, 12, 4162. [Google Scholar] [CrossRef]
- Zhong, X.; Jin, Y.; Ren, H.; Hong, T.; Zheng, J.; Fan, W.; Hong, J.; Chen, Z.; Wang, A.; Lu, H.; et al. Research progress of Bacillus velezensis in plant disease resistance and growth promotion. Front. Ind. Microbiol. 2024, 2, 1442980. [Google Scholar] [CrossRef]
- Jin, P.; Chu, L.; Xuan, Z.; Lin, Z.; Fang, Y.; Pan, X.; Wang, J.; Liu, W.; Miao, W. Bacillus velezensis, a new valuable source of bioactive molecules within plant microbiomes and natural weapons for the biocontrol of plant pathogens. Trop. Plants 2025, 4, e001. [Google Scholar] [CrossRef]
- Cai, X.C.; Liu, C.H.; Wang, B.T.; Xue, Y.R. Genomic and metabolic traits endow Bacillus velezensis CC09 with a potential biocontrol agent in control of wheat powdery mildew disease. Microbiol. Res. 2017, 196, 89–94. [Google Scholar] [CrossRef] [PubMed]
- Liu, H.; Zeng, Q.; Yalimaimaiti, N.; Wang, W.; Zhang, R.; Yao, J. Comprehensive genomic analysis of Bacillus velezensis AL7 reveals its biocontrol potential against Verticillium wilt of cotton. Mol. Genet. Genom. 2021, 296, 1287–1298. [Google Scholar] [CrossRef]
- Wang, M.; Zhang, Y.; Cai, H.; Zhao, X.; Zhu, Z.; Yan, Y.; Yin, K.; Cheng, G.; Li, Y.; Chen, G.; et al. A New Biocontrol Agent Bacillus velezensis SF334 against Rubber Tree Fungal Leaf Anthracnose and Its Genome Analysis of Versatile Plant Probiotic Traits. J. Fungi 2024, 10, 158. [Google Scholar] [CrossRef]
- Liu, Y.; Yin, C.; Zhu, M.; Zhan, Y.; Lin, M.; Yan, Y. Comparative Genomic Analysis of Bacillus velezensis BRI3 Reveals Genes Potentially Associated with Efficient Antagonism of Sclerotinia sclerotiorum (Lib.) de Bary. Genes 2024, 15, 1588. [Google Scholar] [CrossRef]
- Tao, H.; Li, X.; Huo, H.; Cai, Y.; Cai, A. Bacillus velezensis Y6, a Potential and Efficient Biocontrol Agent in Control of Rice Sheath Blight Caused by Rhizoctonia solani. Microorganisms 2024, 12, 1694. [Google Scholar] [CrossRef] [PubMed]
- Assena, M.W.; Pfannstiel, J.; Rasche, F. Inhibitory activity of bacterial lipopeptides against Fusarium oxysporum f.sp. Strigae. BMC Microbiol. 2024, 24, 227. [Google Scholar] [CrossRef] [PubMed]
- Wang, B.; Yang, B.; Peng, H.; Lu, J.; Fu, P. Genome sequence and comparative analysis of fungal antagonistic strain Bacillus velezensis LJBV19. Folia Microbiol. 2023, 68, 73–86. [Google Scholar] [CrossRef] [PubMed]
- Wockenfuss, A.; Chan, K.; Cooper, J.G.; Chaya, T.; Mauriello, M.A.; Yannarell, S.M.; Maresca, J.A.; Donofrio, N.M. A Bacillus velezensis strain shows antimicrobial activity against soilborne and foliar fungi and oomycetes. Front. Fungal Biol. 2024, 5, 1332755. [Google Scholar] [CrossRef]
- Zhang, J.; Yang, F.; Zhang, A.; Guo, Q.; Sun, X.; Zhang, S.; Di, D. Identification of Nigrospora oryzae Causing Leaf Spot Disease in Tomato and Screening of Its Potential Antagonistic Bacteria. Microorganisms 2025, 13, 1128. [Google Scholar] [CrossRef]
- Li, X.J.; Yao, C.X.; Qiu, R.; Bai, J.K.; Liu, C.; Chen, Y.G.; Li, S.J. Isolation, identification, and evaluation of the biocontrol potential of a Bacillus velezensis strain against tobacco root rot caused by Fusarium oxysporum. J. Appl. Microbiol. 2023, 134, lxac049. [Google Scholar] [CrossRef]
- Khan, M.S.; Gao, J.; Chen, X.; Zhang, M.; Yang, F.; Du, Y.; Moe, T.S.; Munir, I.; Xue, J.; Zhang, X. The Endophytic Bacteria Bacillus velezensis Lle-9, Isolated from Lilium leucanthum, Harbors Antifungal Activity and Plant Growth-Promoting Effects. J. Microbiol. Biotechnol. 2020, 30, 668–680. [Google Scholar] [CrossRef]
- Wang, S.; Jin, P.; Zheng, Y.; Kangkang, W.; Chen, J.; Liu, J.; Li, Y. Bacillus velezensis B105-8, a potential and efficient biocontrol agent in control of maize stalk rot caused by Fusarium graminearum. Front. Microbiol. 2024, 15, 1462992. [Google Scholar] [CrossRef]
- Kaboré, K.H.; Kassankogno, A.I.; Adreit, H.; Milazzo, J.; Guillou, S.; Blondin, L.; Chopin, L.; Ravel, S.; Charriat, F.; Barro, M.; et al. Genetic diversity and structure of Bipolaris oryzae and Exserohilum rostratum populations causing brown spot of rice in Burkina Faso based on genotyping-by-sequencing. Front. Plant Sci. 2022, 13, 1022348. [Google Scholar] [CrossRef]
- Tu, C.-K.; Huang, W.-D.; Wang, P.-H.; Lin, W.-L.; Chen, H.-Y.; Rau, S.-T.; Chang, T.-C.; Young, L.-S.; Wang, C.-L.; Lee, M.-H. The rice endophytic bacterium Bacillus velezensis LS123N provides protection against multiple pathogens and enhances rice resistance to wind with increase in yield. Biol. Control 2024, 192, 105507. [Google Scholar] [CrossRef]
- Sun, X.; Qi, X.; Wang, W.; Liu, X.; Zhao, H.; Wu, C.; Chang, X.; Zhang, M.; Chen, H.; Gong, G. Etiology and Symptoms of Maize Leaf Spot Caused by Bipolaris spp. in Sichuan, China. Pathogens 2020, 9, 229. [Google Scholar] [CrossRef] [PubMed]
- Sugawara, F.; Strobel, G.; Fisher, L.E.; Van Duyne, G.D.; Clardy, J. Bipolaroxin, a selective phytotoxin produced by Bipolaris cynodontis. Proc. Natl. Acad. Sci. USA 1985, 82, 8291–8294. [Google Scholar] [CrossRef] [PubMed]
- Gao, Z.; Zhang, B.; Liu, H.; Han, J.; Zhang, Y. Identification of endophytic Bacillus velezensis ZSY-1 strain and antifungal activity of its volatile compounds against Alternaria solani and Botrytis cinerea. Biol. Control 2017, 105, 27–39. [Google Scholar] [CrossRef]
- Liao, J.; Liang, X.; Li, H.; Mo, L.; Mo, R.; Chen, W.; Wei, Y.; Wang, T.; Jiang, W. Biocontrol ability of Bacillus velezensis T9 against Apiospora arundinis causing Apiospora mold on sugarcane. Front. Microbiol. 2023, 14, 1314887. [Google Scholar] [CrossRef]
- Zhao, H.; Liu, K.; Fan, Y.; Cao, J.; Li, H.; Song, W.; Liu, Y.; Miao, M. Cell-free supernatant of Bacillus velezensis suppresses mycelial growth and reduces virulence of Botrytis cinerea by inducing oxidative stress. Front. Microbiol. 2022, 13, 980022. [Google Scholar] [CrossRef]
- Fu, C.; Wan, S.; Yang, P.; Zhao, X.; Yan, Y.; Jiang, S.; Ali, H. Identification of the Ilex macrocarpa anthracnose pathogen and the antifungal potential of the cell-free supernatant of Bacillus velezensis against Colletotrichum fioriniae. Front. Microbiol. 2024, 15, 1419436. [Google Scholar] [CrossRef]
- Arrebola, E.; Jacobs, R.; Korsten, L. Iturin A is the principal inhibitor in the biocontrol activity of Bacillus amyloliquefaciens PPCB004 against postharvest fungal pathogens. J. Appl. Microbiol. 2010, 108, 386–395. [Google Scholar] [CrossRef]
- Li, Y.; Héloir, M.C.; Zhang, X.; Geissler, M.; Trouvelot, S.; Jacquens, L.; Henkel, M.; Su, X.; Fang, X.; Wang, Q.; et al. Surfactin and fengycin contribute to the protection of a Bacillus subtilis strain against grape downy mildew by both direct effect and defence stimulation. Mol. Plant Pathol. 2019, 20, 1037–1050. [Google Scholar] [CrossRef]
- Köhl, J.; Kolnaar, R.; Ravensberg, W.J. Mode of Action of Microbial Biological Control Agents Against Plant Diseases: Relevance Beyond Efficacy. Front. Plant Sci. 2019, 10, 845. [Google Scholar] [CrossRef]
- Fan, H.; Zhang, Z.; Li, Y.; Zhang, X.; Duan, Y.; Wang, Q. Biocontrol of Bacterial Fruit Blotch by Bacillus subtilis 9407 via Surfactin-Mediated Antibacterial Activity and Colonization. Front. Microbiol. 2017, 8, 1973. [Google Scholar] [CrossRef]
- Wu, T.; Xiao, F.; Li, W. Macrolactins: Biological activity and biosynthesis. Mar. Life Sci. Technol. 2021, 3, 62–68. [Google Scholar] [CrossRef] [PubMed]
- Miao, S.; Liang, J.; Xu, Y.; Yu, G.; Shao, M. Bacillaene, sharp objects consist in the arsenal of antibiotics produced by Bacillus. J. Cell. Physiol. 2024, 239, e30974, Correction in J. Cell. Physiol. 2024, 239, e31228 https://doi.org/10.1002/jcp.31228. [Google Scholar] [CrossRef]
- Sun, J.; Qi, X.; Du, C. Biosynthesis and yield improvement strategies of fengycin. Arch. Microbiol. 2025, 207, 90. [Google Scholar] [CrossRef] [PubMed]
- Zimmerman, S.B.; Schwartz, C.D.; Monaghan, R.L.; Pelak, B.A.; Weissberger, B.; Gilfillan, E.C.; Mochales, S.; Hernandez, S.; Currie, S.A.; Tejera, E.; et al. Difficidin and oxydifficidin: Novel broad spectrum antibacterial antibiotics produced by Bacillus subtilis. I. Production, taxonomy and antibacterial activity. J. Antibiot. 1987, 40, 1677–1681. [Google Scholar] [CrossRef] [PubMed]
- Wu, L.; Wu, H.; Chen, L.; Yu, X.; Borriss, R.; Gao, X. Difficidin and bacilysin from Bacillus amyloliquefaciens FZB42 have antibacterial activity against Xanthomonas oryzae rice pathogens. Sci. Rep. 2015, 5, 12975. [Google Scholar] [CrossRef]
- Izumi, M.; Tomita, H.; Miyazaki, K.; Otsuka, R.; Honda, K. Biosynthetic Characterization of Bacillibactin in Thermophilic Bacillaceae and its Potential for In Vitro Mutational Synthesis. Chembiochem 2025, 26, e202400836. [Google Scholar] [CrossRef]
- Abdulmalek, H.W.; Yazgan-Karataş, A. Improvement of Bacilysin Production in Bacillus subtilis by CRISPR/Cas9-Mediated Editing of the 5′-Untranslated Region of the bac Operon. J. Microbiol. Biotechnol. 2023, 33, 410–418. [Google Scholar] [CrossRef]

| Treatment | Experimental Variables | Timing of Biocontrol Agent Addition | |
|---|---|---|---|
| Pathogen | Biocontrol Agent | ||
| Control | Xoo | NB | 12 h after pathogen inoculation |
| Pre-treated | Xoo | AN6 | 12 h before pathogen inoculation |
| Co-treated | Xoo | AN6 | 12 h after pathogen inoculation |
| NB | NB | NB | 12 h after pathogen inoculation |
| Database | Number of Annotated Functional Proteins | Proportion/% |
|---|---|---|
| Nr | 3939 | 97.86 |
| GO | 2714 | 67.43 |
| KEGG | 3875 | 96.27 |
| COG | 2993 | 74.36 |
| Pfam | 2714 | 67.43 |
| Swiss-Prot | 3302 | 82.04 |
| TCDB | 515 | 12.80 |
| CAZy | 156 | 3.88 |
| Gene Cluster | Secondary Metabolite(s) | Genome Location | Most Similar Known Cluster | Similarity Confidence |
|---|---|---|---|---|
| Cluster 1 | NRPS | 322,200–387,607 | Surfactin | High |
| Cluster 2 | PKS-like | 924,057–965,301 | ||
| Cluster 3 | Terpene | 1,047,341–1,068,081 | ||
| Cluster 4 | Lanthipeptide class ii | 1,188,574–1,217,462 | ||
| Cluster 5 | TransAT-PKS | 1,384,025–1,472,258 | Macrolactin H | High |
| Cluster 6 | TransAT-PKS, T3PKS, and NRPS | 1,690,949–1,801,042 | Bacillaene | High |
| Cluster 7 | NRPS, transAT-PKS, and betalactone | 1,865,673–2,003,474 | Fengycin | High |
| Cluster 8 | Terpene | 2,028,701–2,050,584 | ||
| Cluster 9 | T3PKS | 2,113,902–2,155,002 | ||
| Cluster 10 | TransAT-PKS | 2,269,988–2,376,170 | Difficidin | High |
| Cluster 11 | Terpene precursor | 2,399,464–2,420,354 | ||
| Cluster 12 | NRP metallophore, NRPS, and RiPP-like | 3,000,874–3,052,665 | Bacillibactin | High |
| Cluster 13 | Other | 3,588,975–3,630,393 | Bacilysin | High |
Disclaimer/Publisher’s Note: The statements, opinions and data contained in all publications are solely those of the individual author(s) and contributor(s) and not of MDPI and/or the editor(s). MDPI and/or the editor(s) disclaim responsibility for any injury to people or property resulting from any ideas, methods, instructions or products referred to in the content. |
© 2025 by the authors. Licensee MDPI, Basel, Switzerland. This article is an open access article distributed under the terms and conditions of the Creative Commons Attribution (CC BY) license (https://creativecommons.org/licenses/by/4.0/).
Share and Cite
Yang, L.; Gu, A.; Deng, W.; Che, S.; Zhang, J.; Zhang, J.; Kui, L.; Tu, J.; Dong, W.; An, H.; et al. Isolation and Genome-Based Characterization of Bacillus velezensis AN6 for Its Biocontrol Potential Against Multiple Plant Pathogens. Microorganisms 2025, 13, 2701. https://doi.org/10.3390/microorganisms13122701
Yang L, Gu A, Deng W, Che S, Zhang J, Zhang J, Kui L, Tu J, Dong W, An H, et al. Isolation and Genome-Based Characterization of Bacillus velezensis AN6 for Its Biocontrol Potential Against Multiple Plant Pathogens. Microorganisms. 2025; 13(12):2701. https://doi.org/10.3390/microorganisms13122701
Chicago/Turabian StyleYang, Liping, Anyu Gu, Wei Deng, Shu Che, Jianhua Zhang, Jinwen Zhang, Limei Kui, Jian Tu, Wei Dong, Hua An, and et al. 2025. "Isolation and Genome-Based Characterization of Bacillus velezensis AN6 for Its Biocontrol Potential Against Multiple Plant Pathogens" Microorganisms 13, no. 12: 2701. https://doi.org/10.3390/microorganisms13122701
APA StyleYang, L., Gu, A., Deng, W., Che, S., Zhang, J., Zhang, J., Kui, L., Tu, J., Dong, W., An, H., Guan, J., Fan, J., Shen, X., & Li, X. (2025). Isolation and Genome-Based Characterization of Bacillus velezensis AN6 for Its Biocontrol Potential Against Multiple Plant Pathogens. Microorganisms, 13(12), 2701. https://doi.org/10.3390/microorganisms13122701

